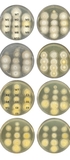
Epimutations in Mucor drug resistance

02/06/2026
Research Article
Regulating synaptic vesicle size and release
The endocytic protein AP180 regulates synaptic vesicle recycling during neurotransmission, but how are vesicle size and release frequency determined? Yu Wang, Lanxi Wu, Jihong Bai and co-workers show that the AP180 assembly domain regulates synaptic vesicle size and release fidelity in C. elegans via actin binding, revealing how vesicle morphology influences neurotransmission..
Image credit: pbio.3003643

Connect with Us